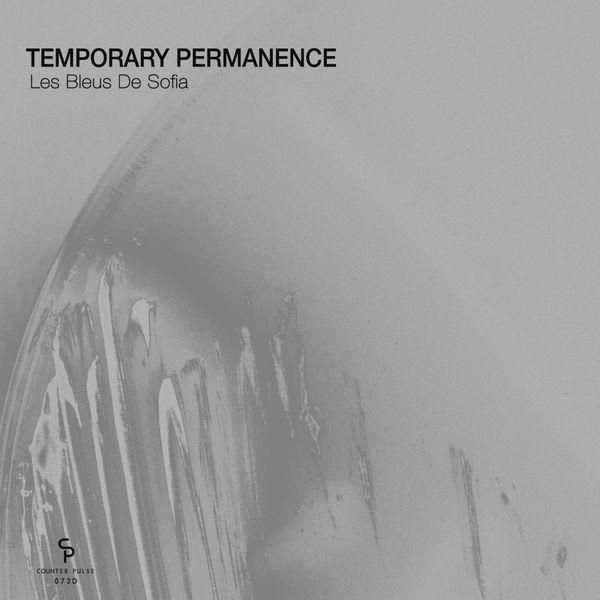

00-temporary_permanence-les_bleus_de_sofia-(cp072d)-16bit-web-flac-2018
0 like(s)
Image Tools
Embed Code
To change the image size add /{Size} at the end of the link in <img.>
BBCode
Sister
11/08/2023 (2 years ago)